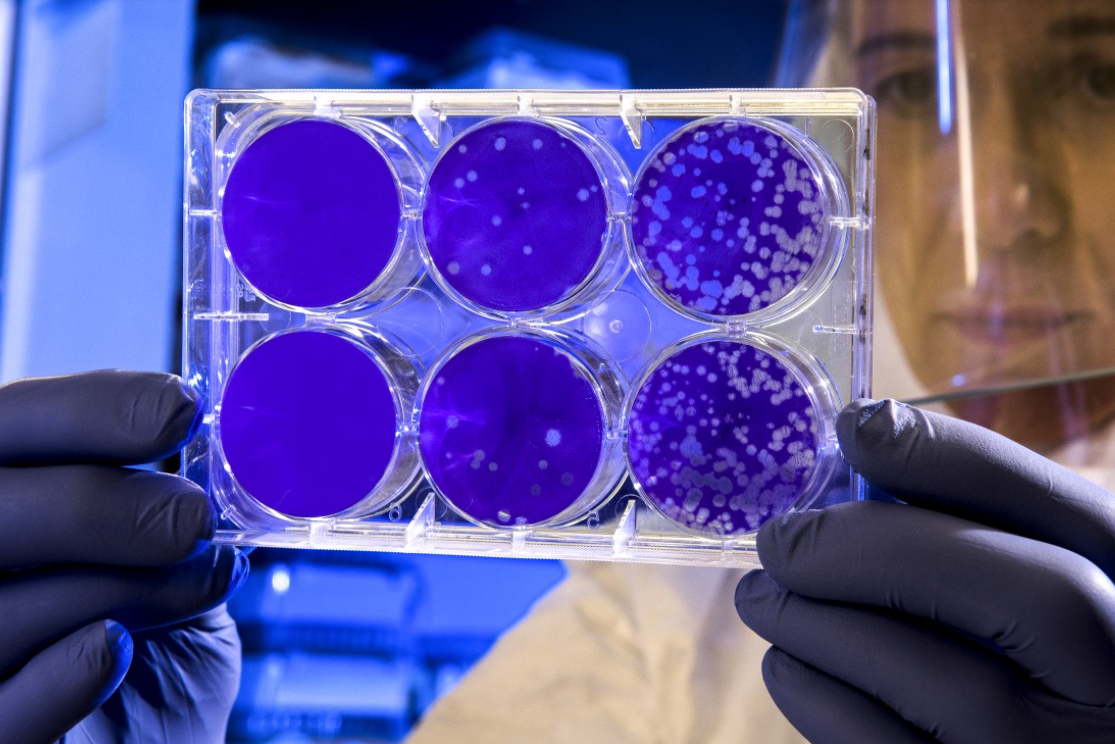

"The largest increase in cases has been seen in South-East Asia (especially India) and Western Pacific regions. All regions except the African continent reported an increase in deaths, with the largest increase, of 46%, in South-East Asia," WHO said.
The highest number of new cases was in India (more than 513 000 new cases; up 38%), Brazil (505 000; down 5%), USA (444 000; +5%), Turkey (265 000; +43%) and France (244 000; -4%).
In total, according to WHO, there have been more than 131.4 million cases of infection and 2.8 million deaths worldwide. More than 434 000 new infections and 6.6 000 deaths have been identified over the past 24 hours.
Johns Hopkins University estimates there have been more than 132.2 million infections and 2.8 million deaths worldwide. In the past 24 hours, there has been an increase of 490,000 new infections and 7,400 deaths.
source: who.org
The highest number of new cases was in India (more than 513 000 new cases; up 38%), Brazil (505 000; down 5%), USA (444 000; +5%), Turkey (265 000; +43%) and France (244 000; -4%).
In total, according to WHO, there have been more than 131.4 million cases of infection and 2.8 million deaths worldwide. More than 434 000 new infections and 6.6 000 deaths have been identified over the past 24 hours.
Johns Hopkins University estimates there have been more than 132.2 million infections and 2.8 million deaths worldwide. In the past 24 hours, there has been an increase of 490,000 new infections and 7,400 deaths.
source: who.org